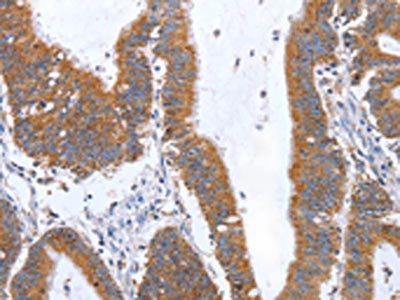

-
中文名稱:TNF兔多克隆抗體
-
貨號:CSB-PA954619
-
規格:¥1100
-
圖片:
-
The image on the left is immunohistochemistry of paraffin-embedded Human colon cancer tissue using CSB-PA954619(TNF Antibody) at dilution 1/35, on the right is treated with fusion protein. (Original magnification: ×200)
-
The image on the left is immunohistochemistry of paraffin-embedded Human esophagus cancer tissue using CSB-PA954619(TNF Antibody) at dilution 1/35, on the right is treated with fusion protein. (Original magnification: ×200)
-
-
其他:
產品詳情
-
Uniprot No.:
-
基因名:
-
別名:APC1 antibody; APC1 protein antibody; Cachectin antibody; DIF antibody; Differentiation inducing factor antibody; Macrophage cytotoxic factor antibody; Tnf antibody; TNF superfamily member 2 antibody; TNF superfamily, member 2 antibody; TNF, macrophage derived antibody; TNF, monocyte derived antibody; TNF-a antibody; TNF-alpha antibody; TNFA antibody; TNFA_HUMAN antibody; TNFSF2 antibody; Tumor necrosis factor (TNF superfamily member 2) antibody; Tumor necrosis factor alpha antibody; Tumor necrosis factor antibody; Tumor necrosis factor ligand superfamily member 2 antibody; Tumor Necrosis Factor, Membrane Form antibody; Tumor necrosis factor, soluble form antibody
-
宿主:Rabbit
-
反應種屬:Human
-
免疫原:Fusion protein of Human TNF
-
免疫原種屬:Homo sapiens (Human)
-
標記方式:Non-conjugated
-
抗體亞型:IgG
-
純化方式:Antigen affinity purification
-
濃度:It differs from different batches. Please contact us to confirm it.
-
保存緩沖液:-20°C, pH7.4 PBS, 0.05% NaN3, 40% Glycerol
-
產品提供形式:Liquid
-
應用范圍:ELISA,IHC
-
推薦稀釋比:
Application Recommended Dilution ELISA 1:2000-1:5000 IHC 1:25-1:100 -
Protocols:
-
儲存條件:Upon receipt, store at -20°C or -80°C. Avoid repeated freeze.
-
貨期:Basically, we can dispatch the products out in 1-3 working days after receiving your orders. Delivery time maybe differs from different purchasing way or location, please kindly consult your local distributors for specific delivery time.
-
用途:For Research Use Only. Not for use in diagnostic or therapeutic procedures.
相關產品
靶點詳情
-
功能:Cytokine that binds to TNFRSF1A/TNFR1 and TNFRSF1B/TNFBR. It is mainly secreted by macrophages and can induce cell death of certain tumor cell lines. It is potent pyrogen causing fever by direct action or by stimulation of interleukin-1 secretion and is implicated in the induction of cachexia, Under certain conditions it can stimulate cell proliferation and induce cell differentiation. Impairs regulatory T-cells (Treg) function in individuals with rheumatoid arthritis via FOXP3 dephosphorylation. Upregulates the expression of protein phosphatase 1 (PP1), which dephosphorylates the key 'Ser-418' residue of FOXP3, thereby inactivating FOXP3 and rendering Treg cells functionally defective. Key mediator of cell death in the anticancer action of BCG-stimulated neutrophils in combination with DIABLO/SMAC mimetic in the RT4v6 bladder cancer cell line. Induces insulin resistance in adipocytes via inhibition of insulin-induced IRS1 tyrosine phosphorylation and insulin-induced glucose uptake. Induces GKAP42 protein degradation in adipocytes which is partially responsible for TNF-induced insulin resistance. Plays a role in angiogenesis by inducing VEGF production synergistically with IL1B and IL6.; The TNF intracellular domain (ICD) form induces IL12 production in dendritic cells.
-
基因功能參考文獻:
- Genetic predisposition to rheumatoid arthritis in Russian population in the Republic of Karelia is associated with the presence of the GG TNF-alpha genotype. PMID: 30225702
- Treatment with 30 microg/ml curcumin also significantly diminishes the protein production of TNFalpha in Behcet's disease patients (p < .01) and healthy controls (p < .05) M1 macrophages. PMID: 29806793
- the protective role of the A allele in TNF-alpha 238A/G but not TNF-alpha 308A/G against the occurrence of juvenile idiopathic arthritis in the Caucasian population (Meta-Analysis) PMID: 30412082
- TNF-alpha expressed regionally in Epicardial Adipose Tissue may exert potent effects on the progression of coronary atherosclerosis PMID: 28931782
- The effect of the pro-inflammatory diet on concentrations of TNF-alpha was more pronounced in pregnant women reporting higher levels of stress. PMID: 30200631
- TNF-alpha -308G/A polymorphism is not associated with the risk to develop of bullous pemphigoid and alopecia areata in our Iranian cohort PMID: 29843231
- data support that only the promoter single-nucleotide polymorphism (SNP) rs1800629 within the TNF-alpha gene is associated with increased risk for developing Graves' disease (GD), especially in European population. Future large-scale studies are required to validate the associations between TNF-alpha gene and GD. PMID: 29440561
- We studied 173 polymorphisms to establish an association with the response to anti-TNF drugs in patients with moderate-to-severe plaque psoriasis (N=144). PMID: 27670765
- The SNP rs4819554 in the promoter region of IL17RA significantly influences the response to anti-TNF drugs at week 12. PMID: 27670766
- TNF-alpha promoter gene polymorphisms and/or haplotypes are risk factors of Nephrotic syndrome and resistance to steroid among Egyptian children PMID: 28803697
- The findings of this study demonstrated that polymorphism in TNF-alpha gene might be a risk factor for nasal polyposis in the north part of Iran and the minor frequency of G308A allele in the current study is slightly more than other major populations. PMID: 30003390
- results suggest, the interplay of pro-inflammatory cytokines IFN-gamma derived from CD4+T lymphocytes and TNF-alpha from CD14+ cells has no direct additive impact on parasite replication but induces IL-4 production. PMID: 29953494
- The single nucleotide polymorphisms rs361525, rs1800629, and rs17999645 of tumor necrosis factor-alpha were significantly correlated with the diagnosis of cervical cancer PMID: 29940817
- Rs11541076 in IRAK3, a negative regulator of TLR signalling, as a predictor of anti-TNF treatment response. PMID: 27698401
- In this Brazilian population, TNF and IL17 gene polymorphisms responsible for the expression of important inflammatory cytokines were associated with overall spondyloarthritis and, specifically, with ankylosing spondylitis and psoriatic arthritis, regardless of gender and HLA-B27 PMID: 29849482
- by restraining TNFR1 at the cell surface via sialylation, ST6Gal-I acts as a functional switch to divert signaling toward survival. These collective findings point to a novel glycosylation-dependent mechanism that regulates the cellular response to TNF and may promote cancer cell survival within TNF-rich tumor microenvironments. PMID: 29233887
- The TNF*A allele confer susceptibility to AIH in the Tunisian patients and is associated with increased production of TNF-alpha. Anti-TNF antibodies could be an alternative to the use of corticotherapy and may avoid the exacerbated immune response in Autoimmune hepatitis. PMID: 29845365
- Impairment in TNF, IL-1beta, and IL-17 production upon stimulation with mycobacterial antigens may contribute to the increased susceptibility to M. tuberculosis infection observed in HTLV-1 infected individuals. PMID: 29523325
- LL was significantly negatively correlated with PGC-1alpha, TNF-alpha, and IL-6 mRNA expressions. PGC-1alpha mRNA expression levels in paraspinal muscles may be affected by lumbar kyphosis. PMID: 30233161
- TNF-alpha-308G>A polymorphism affects the overall survival of cancer patients and is a potential therapeutic target for cancer. PMID: 30407345
- Many inflammatory pathologies are now recognized to be driven by aberrant TNF-induced cell death, which, in most circumstances, depends on the kinase Receptor-interacting serine/threonine-protein kinase 1 (RIPK1). [review] PMID: 29217118
- High TNF-alpha expression is associated with retinopathy of prematurity. PMID: 29274846
- Tumour necrosis factor-alpha selectively reduces BMPR-II transcription and mediates post-translational BMPR-II cleavage via the sheddases, ADAM10 and ADAM17 in pulmonary artery smooth muscle cells. PMID: 28084316
- Polymorphisms of IL-1betab and TNF-a are not a risk of ICC, but an individual with O. viverrini infection has an effect on all genotypes of the TNF-alpha gene that might promote intrahepatic cholangiocarcinoma . Primary prevention of intrahepatic cholangiocarcinoma in high-risk areas is based on efforts to reduce O. viverrini infection. PMID: 30139338
- In placenta, when gestational age was controlled for, partial correlation revealed a significant positive correlation between TNF-alpha and MMP-9 only in the second trimester. PMID: 28820024
- Study shows that in human endometrial stromal cells, high tumor necrosis factor levels negatively affect the insulin action through decreased adiponectin signaling and glucose transporter type 4 protein. This could explain the failures observed in endometrial function of obese women with polycystic ovary syndrome. PMID: 28946816
- Three single nucleotide polymorphisms (SNPs) within P2X4R and two SNPs within CAMKK2 influenced concentrations of TNFalpha in peripheral blood mononuclear cells, but these SNP did not associate with risk for HIV-associated sensory neuropathy in South Africans. PMID: 29428485
- Results indicated that the proinflammatory cytokine TNF-alpha impairs endothelial tight junctions and promotes monocyte-endothelial cell adhesion by upregulating beta-site amyloid precursor protein enzyme 1 expression through activating PKC signaling and sequentially cleaving alpha-2, 6-sialic acid transferase 1. PMID: 28091531
- These findings reveal that PrP enhances the responses to TNF-alpha, promoting proinflammatory cytokine production, which may contribute to inflammation and tumorigenesis. PMID: 28900035
- This study found that the protein and mRNA expression levels of the cytokines TNF-alpha is significantly increased. PMID: 28476335
- Taking together, these results suggest that Wnt/beta-catenin signal pathway activation-dependent up-regulation of syncytin-1 contributes to the pro-inflammatory factor TNF-alpha-enhanced fusion between oral squamous cell carcinoma cells and endothelial cells. PMID: 28112190
- Data suggest that, in children with pediatric obesity, lifestyle weight-loss intervention results in down-regulation of serum cardiotrophin-1 (CTF1), interleukin-6 (IL6), and tumor necrosis factor-alpha (TNFA); expression of CTF1, IL6, and TNFA is also down-regulated in peripheral blood mononuclear cells after improvement in adiposity, body mass index, and waist-hip ratio. PMID: 28749076
- TNFalpha differently regulated the levels of PPARalpha, LXRalpha, and LXRbeta binding to the apoA-I gene promoter in THP-1 cells. Obtained results suggest a novel tissue-specific mechanism of the TNFalpha-mediated regulation of apoA-I gene in monocytes and macrophages and show that endogenous ApoA-I might be positively regulated in macrophage during inflammation. PMID: 29442267
- this is the first evidence to suggest that TET2 mutations promote clonal dominance with aging by conferring TNFalpha resistance to sensitive bone marrow progenitors while also propagating such an inflammatory environment. PMID: 29195897
- Anti-rotavirus effect of TNF-alpha was achieved by NFkappaB-regulated genes via the activation of classical nuclear factor kappaB (NF-kappaB) signaling. PMID: 29859235
- Results revealed that heterozygous genotype GA of TNF-alpha-238 (rs 361525) SNP significantly increased the risk of adverse-outcome (mortality rate), regardless of organ dysfunction or severity of sepsis. PMID: 29978383
- in the patients with primary depression, depressive symptoms were associated with TNF-alpha PMID: 30148175
- Addition of TNFalpha to podocytes causes CD80 upregulation, actin reorganization and podocyte injury. PMID: 29022109
- The results of the study suggest that the levels of C-reactive protein and tumor necrosis factor-alpha are important diagnostic markers of inflammation in patients with chronic pancreatitis and type 2 diabetes mellitus. PMID: 30280549
- TNF-alpha and IL-10 treatment can affect the expression of ICAM-1 and CD31 in human coronary artery endothelial cells. PMID: 29949812
- the results of the present study suggested that overexpression of KLF15 in Eahy926 cells exhibited a protective effect against TNFalpha induced dysfunction via activation of Nrf2 signaling and inhibition of nuclear factor kappaB signaling. PMID: 29956764
- The present study demonstrated the ability of 30 and 100 ng/ml TIMP3 to attenuate migration and proliferation, and to inhibit the activity of MMP2, MMP9 and TNFalpha secretion of NA SMCs. In conclusion, TIMP3 may be considered a potential therapeutic drug for use in a novel drugeluting stent, to attenuate the progressive dilation of the aortic NA. PMID: 29956789
- Elevated A20 promotes TNF-induced and RIPK1-dependent intestinal epithelial cell death PMID: 30209212
- TNF-alpha GG genotype at -238 and GG haplotype at positions -308 and -238 were associated with Kawasaki disease in an Iranian population. PMID: 27455075
- We have shown that a TNFalpha gene polymorphism, rs1800629, is highly significantly associated with postmenopausal osteoporosis and BMD in the female Han Chinese population PMID: 29481288
- allele -308 A TNF-alpha may have a role in progression of rheumatoid arthritis in a North Indian population PMID: 28748515
- ATF3 mediates the inhibitory action of TNF-alpha on osteoblast differentiation and that the TNF-alpha-activated JNK pathway is responsible for the induction of Atf3 expression. PMID: 29605296
- TNF-alpha, DKK1, and OPG have roles in pathogenesis of knee osteoarthritis PMID: 28676900
- Btk acts in the TLR7/8 pathway and mediates Ser-536 phosphorylation of p65 RelA and subsequent nuclear entry in primary human macrophages. PMID: 29567473
- Results indicated that prolonged tumor necrosis factor (TNFalpha) exposure could have detrimental consequences to endothelial cells by causing senescence and, therefore, chronically increased TNFalpha levels might possibly contribute to the pathology of chronic inflammatory diseases by driving premature endothelial senescence. PMID: 28045034
顯示更多
收起更多
-
相關疾病:Psoriatic arthritis (PSORAS)
-
亞細胞定位:Cell membrane; Single-pass type II membrane protein.; [Tumor necrosis factor, membrane form]: Membrane; Single-pass type II membrane protein.; [Tumor necrosis factor, soluble form]: Secreted.; [C-domain 1]: Secreted.; [C-domain 2]: Secreted.
-
蛋白家族:Tumor necrosis factor family
-
數據庫鏈接:
Most popular with customers
-
-
YWHAB Recombinant Monoclonal Antibody
Applications: ELISA, WB, IHC, IF, FC
Species Reactivity: Human, Mouse, Rat
-
Phospho-YAP1 (S127) Recombinant Monoclonal Antibody
Applications: ELISA, WB, IHC
Species Reactivity: Human
-
-
-
-
-